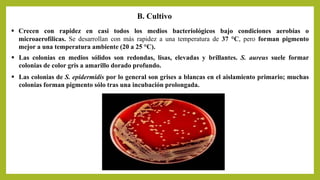
B. Cultivo
 Crecen con rapidez en casi todos los medios bacteriológicos bajo condiciones aerobias o
microaerofílicas. Se desarrollan con más rapidez a una temperatura de 37 °C, pero forman pigmento
mejor a una temperatura ambiente (20 a 25 °C).
 Las colonias en medios sólidos son redondas, lisas, elevadas y brillantes. S. aureus suele formar
colonias de color gris a amarillo dorado profundo.
 Las colonias de S. epidermidis por lo general son grises a blancas en el aislamiento primario; muchas
colonias forman pigmento sólo tras una incubación prolongada.

Este documento describe las características de los estafilococos grampositivos. Menciona que existen al menos 45 especies de estafilococos, siendo las más importantes clínicamente S. aureus, S. epidermidis, S. lugdunensis y S. saprophyticus. Describe algunas de sus características morfológicas, de cultivo, enzimas y toxinas producidas, y manifestaciones patológicas asociadas a infecciones por estafilococos.